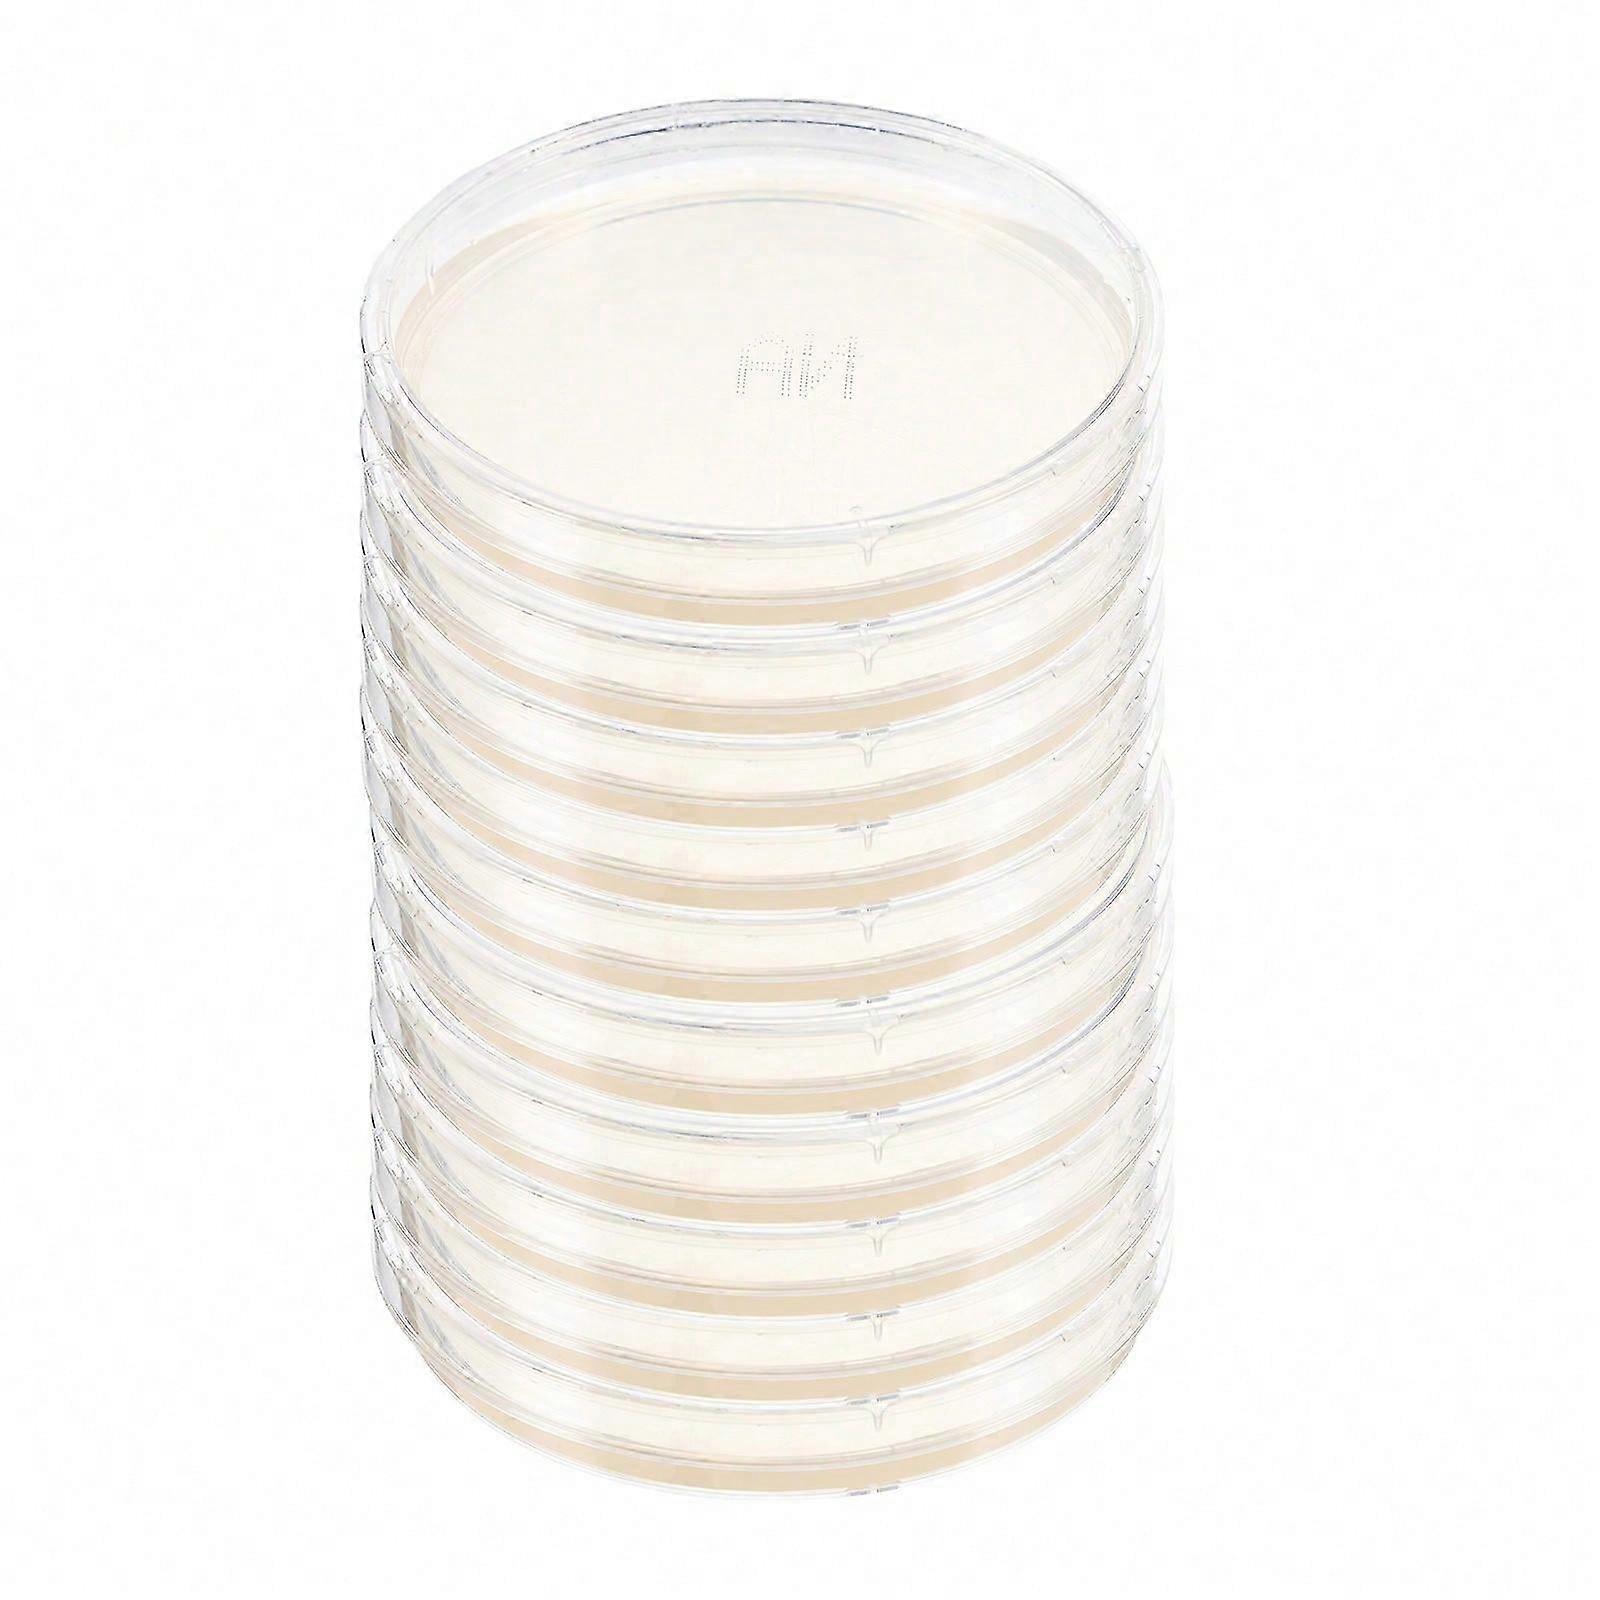

Petri Plates Nutrient Agar Plates Agar Petri Plates Round Transparent Medical Research Scientists 3.54X3.54X0.79in Isolation 10Pcs
+ $29.99 Shipping
Petri Plates Nutrient Agar Plates Agar Petri Plates Round Transparent Medical Research Scientists 3.54X3.54X0.79in Isolation 10Pcs
- Brand: Unbranded
Petri Plates Nutrient Agar Plates Agar Petri Plates Round Transparent Medical Research Scientists 3.54X3.54X0.79in Isolation 10Pcs
- Brand: Unbranded
Price: |
In stock
We accept the following payment methods
Description
- Brand: Unbranded
- Category: Petri Dishes
-
Size: 9.00X9.00X2.00CM
-
Colour: Transparent
- Fruugo ID: 414846968-876180110
- EAN: 5319223746653
Delivery & Returns
Dispatched within 24 hours
-
STANDARD: $29.99 - Delivery between Wed. 15 October 2025–Wed. 22 October 2025
Shipping from China.
We do our best to ensure that the products that you order are delivered to you in full and according to your specifications. However, should you receive an incomplete order, or items different from the ones you ordered, or there is some other reason why you are not satisfied with the order, you may return the order, or any products included in the order, and receive a full refund for the items. View full return policy